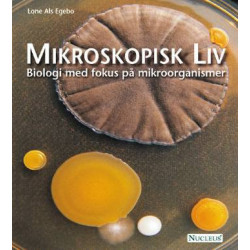
Mikroskopisk Liv: Biologi med fokus på mikroorganismer

Ingen varer
Nucleus Forlag
Visning: Type : Alle | Sprog : Alle | Format : Alle
-
Bemærk: Kan leveres før jul.
Mikroskopisk Liv: Biologi med fokus på mikroorganismer (Bog, Hæftet, Dansk)Bakterier, arkæer, alger, svampe og protozoer - det vrimler med mikroskopisk liv omkring os. De usynlige mikroorganismer er uundværlige aktører på... Læs mere
Levering: 3 - 8 hverdageNedsat pris! -
Bemærk: Kan leveres før jul.
Fysiologibogen (Bog, Indbundet, Dansk)Fysiologibogen 2. udgave er en omarbejdet, opdateret og udvidet udgave af Fysiologibogen – den levende krop. Alle kapitler dækker A-niveauet.
Levering: 3 - 8 hverdageNedsat pris! -
Bemærk: Kan leveres før jul.
Bioteknologi A - Bind 1 (Bog, Indbundet, Dansk)Første bind i en serie af 3 bøger til STX-faget Bioteknologi A. Bind 1 er skrevet til 1.g og indeholder 7 kapitler.
Levering: På eget lager, 1 - 2 hverdageNedsat pris! -
Bemærk: Kan leveres før jul.
Undersøg naturen: elevens bog (Bog, Hæftet, Dansk)Bogen er et praktisk arbejdsredskab i biologiundervisningen på alle de gymnasiale niveauer. Den vil også vare anvendelig i naturvidenskabelig faggruppe,... Læs mere
Levering: 3 - 8 hverdageNedsat pris! -
Bemærk: Kan leveres før jul.
Genetikbogen B+A: genetik, genteknologi og evolution (Bog, Indbundet, Dansk)Bogen er en efterfølger til Genetikbogen, men opdateret og med nye emner og eksempler.Bogen er skrevet til biologiundervisningen på de gymnasiale uddannelsers B- og A-niveau.
Levering: 3 - 8 hverdageNedsat pris! -
Bemærk: Kan leveres før jul.
Menneskets genetik: en grundbog for sygeplejerskestuderende (Bog, Hæftet, Dansk)Der er sket store ændringer i forhold til 1. udgave. Kapitler er revideret og opdateret, nogle kapitler er udvidet, og nogle kapitler er slået... Læs mere
Levering: 3 - 8 hverdageNedsat pris! -
Bemærk: Kan leveres før jul.
Mikrobiologi: en grundbog for sygeplejestuderende (Bog, Dansk)Salmonella, fugleinfluenza, MRSA og hospitalsinfektioner hører vi om næsten dagligt. Nye bakterier og virus dukker til stadighed op og forårsager alvorlige... Læs mere
Levering: 3 - 8 hverdageNedsat pris! -
Bemærk: Kan leveres før jul.
Biolex: biologisk leksikon for ungdomsuddannelserne (Bog, Dansk)Biolex er et overskueligt og pædagogisk opbygget opslagsværk over de almindeligst forekommende biologiske fagudtryk og begreber fra alle de vigtigste... Læs mere
Levering: 3 - 8 hverdageNedsat pris! -
Bemærk: Kan leveres før jul.
Biokemibogen: liv, funktion, molekyle (Bog, Hardback, Dansk)2. udgave af Biokemibogen er udvidet med Appendiks 4 og Appendiks 5 som uddyber stofskifteprocesserne og enzymkinetikken. Tekst og figurer er revideret flere steder, dog... Læs mere
Levering: 3 - 8 hverdageNedsat pris! -
Bemærk: Kan leveres før jul.
Biologi i udvikling: (C) (Bog, Hardback, Dansk)Biologi i udvikling er en grundbog skrevet til undervisningen i biologi på C-niveau. Den dækker læreplanernes kernestof for de gymnasiale uddannelser og giver samtidig mulighed for fordybelse i bogens forskellige temaer.
Levering: 3 - 8 hverdageNedsat pris! -
Bemærk: Kan leveres før jul.
Undersøg naturen: Lærerens bog (Bog, Hæftet, Dansk)Bogen er et praktisk arbejdsredskab i biologiundervisningen på alle de gymnasiale niveauer. Den vil også være anvendelig i naturvidenskabelig faggruppe,... Læs mere
Levering: 3 - 8 hverdage -
Bemærk: Kan leveres før jul.
Fysiologibogen: den levende krop (Bog, Hardback, Dansk)Fysiologibogen omhandler kroppens fysiologi. Den giver en solid faglig gennemgang med afstikkere til andre organismers fysiologi og har temaer om bl.a. stress, stoffer og... Læs mere
Levering: 3 - 8 hverdage